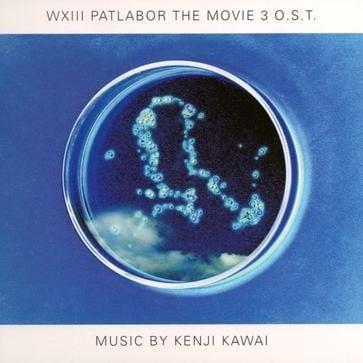
WXIII: Patlabor the Movie 3 Original Soundtrack

动画
机动警察 十三号废弃物
WXIII 機動警察パトレイバー
2000年、東京湾に輸送機(フロンティア航空236便)が墜落し、乗員全員が死亡する事故が発生した。事故後、東京湾岸の各所で何者かによるレイバー襲撃事件が連続して発生し、警視庁城南署の刑事である…
2002.03.30
7.3
817 收藏
Subject
机动警察 十三号废弃物
WXIII 機動警察パトレイバー
2000年、東京湾に輸送機(フロンティア航空236便)が墜落し、乗員全員が死亡する事故が発生した。事故後、東京湾岸の各所で何者かによるレイバー襲撃事件が連続して発生し、警視庁城南署の刑事である久住と秦は各所で聞き込み捜査を進め、墜落事件の後に巨大なハゼが釣れていたこと、墜落した輸送機の貨物コンテナに不審な点があることなどを突き止める。 その後、6月8日の雨の夜に若者の集うディスコクラブ「バビロン」で、車に乗ったカップルの惨殺死体が発見される。時を同じくして、「バビロン」の近隣にあるバビロン工区の水上コンテナ備蓄基地で突如警報が作動し、施設内が停電すると共に内部の職員と連絡がとれなくなる事態が発生した。 近くを走行中のパトカー(城南4)に偶然乗っていた久住と秦は、警備員の通報を受けパトカーに乗る警官らと共に現場に急行。警備員たちと共に施設内部へと分け入った。しかしそこで彼らが遭遇したのは、廃棄物13号(WXIII)と名…
首播 2002.03.30评分 7.3817 收藏1 集
Episodes
章节推进
EP 1
未命名章节
Characters
登场角色
Staff
制作人员
Related
关联条目

动画
机动警察
機動警察パトレイバー
暂无简介
未知日期
--
-- 收藏

动画
机动警察 OVA
機動警察パトレイバー アーリーデイズ
暂无简介
未知日期
--
-- 收藏

动画
机动警察迷你版
ミニパト
暂无简介
未知日期
--
-- 收藏

书籍
机动警察PATLABOR
機動警察パトレイバー
暂无简介
未知日期
--
-- 收藏

音乐
WXIII: Patlabor the Movie 3 Original Soundtrack
WXIII 機動警察パトレイバー ORIGINAL SOUNDTRACK
暂无简介
未知日期
--
-- 收藏

书籍
機動警察パトレイバー 完全設定資料集 vol.5 -劇場編③-
機動警察パトレイバー 完全設定資料集 vol.5 -劇場編③-
暂无简介
未知日期
--
-- 收藏

书籍
机动警察艺术集
機動警察パトレイバーartworks集
暂无简介
未知日期
--
-- 收藏

书籍
機動警察パトレイバー30周年展MEMORIAL BOOKLET
機動警察パトレイバー30周年展MEMORIAL BOOKLET
暂无简介
未知日期
--
-- 收藏